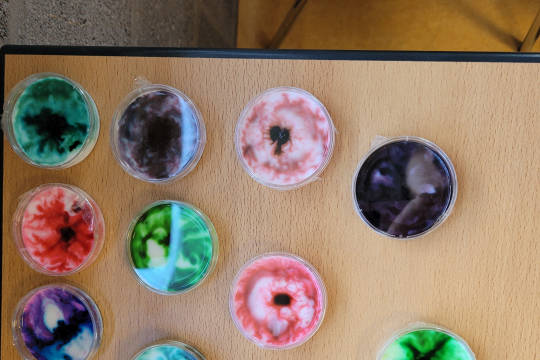
Printemps des Sciences

Le Printemps des Sciences à la HEPL
Mercredi 2 avril 2025 - 10:33
Le 24 mars, le Campus Verviers a accueilli plus de 200 élèves de 5e et 6e primaire dans le cadre du Printemps des Sciences. Des étudiants des Bacheliers en Construction, en Soins infirmiers et du Master Ingénieur ont proposés 17 ateliers de découvertes et de manipulations scientifiques autour notamment de la chimie, la construction, la mécanique, l’électronique, la physique, la santé et la diététique.
Les élèves ont par exemple eu l’occasion de gonfler des ballons et faire décoller des bouteilles-fusées grâce à la réaction chimique entre le vinaigre blanc et le bicarbonate. Ils ont fabriqué des lampes à lave à l’aide d’un mélange d’eau et d’huile, construit des maquettes de ponts, piloté des voitures téléguidées, allumé une ampoule à l’aide d’un citron, ou bien fait l’expérience de la réalité virtuelle.
C’est la tête remplie de souvenirs que les élèves sont repartis à la fin de la matinée. Ils ont eu la chance grâce à nos étudiants de découvrir le vaste monde des sciences, accessible via les nombreuses formations techniques et scientifiques de la HEPL !
Découvrez nos Bacheliers et Masters par ici : https://hepl.be/fr/formations